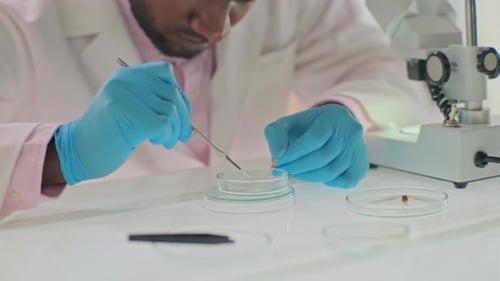
Scientist Working with Sample in Laboratory

Plant Scientist at Work in Laboratory
By PressmasterOne great value subscription from $16.50/month
- Unlimited downloads of 27+ million creative assets
- AI Tools: video, image and more
- Lifetime commercial license
- Easy cancellation
Already have an account? Sign in
Attributes
- Length
- 0:23
- Resolution
- 3840 x 2160
- File Size
- 1.54 GB
- Frame Rate
- 25 fps
- Alpha Channel
- No
- Looped
- No
- Video Encoding
- Apple ProRes 422
- Orientation
- Horizontal
- Commercial License
- Further Information
Description
In a sterile laboratory environment, an adult man wearing safety glasses and blue gloves uses a tool to transfer something on a clear petri dish, then adjusts a microscope. He then peers into the microscope. A woman and a man stand in the background, wearing lab coats and looking at a tablet. Test tubes, paperwork and graphs are also on the counter. This clip is useful for projects about medical research, science, and technology.
All
Music
Sound Effects